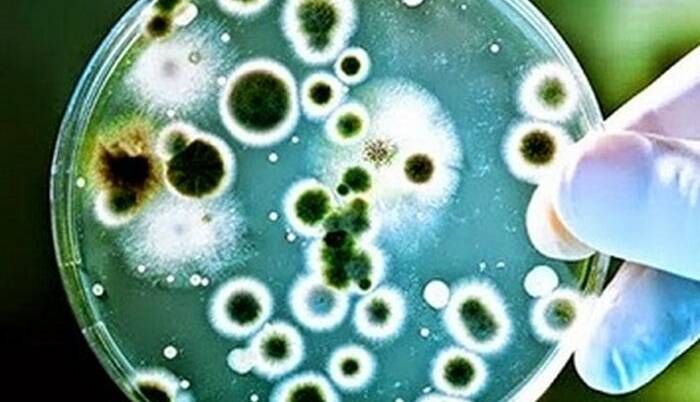

یکشنبه 26 آبان 1404 - 20:35
شناسایی 8 مبتلا به بیماری سیاه زخم در چهارمحال و بختیاری
ایرنا/ رییس مرکز بهداشت چهارمحال و بختیاری با اشاره به شناسایی یک کانون بیماری سیاه زخم و شناسایی ۲ بیمار در شهرستان کوهرنگ در هفته گذشته گفت: از ابتدای سالجاری تاکنون هشت نفر مبتلا به سیاه زخم (شاربن) در استان شناسایی شده است.
مهربان صادقی، رییس مرکز بهداشت چهارمحال و بختیاری افزود: سیاه زخم یا بیماری شاربن از بیماریهای مشترک بین انسان و حیوان است که در حیوانات از جمله گاو، گوسفند، بز به طور ناگهانی و به شکل فوق حاد، حاد ، تحت حاد و مزمن ظاهر و به سرعت منجر به مرگ حیوان میشود.
وی گفت: در سالگذشته ۱۵ نفر در استان به این بیماری مبتلا شدند که بیشترین موارد برای شهرستان کوهرنگ با ۹ مورد، شهرکرد با ۳ مورد، اردل با ۲ مورد و فلارد یک مورد ثبت شد.
صادقی افزود: این بیماری بیشتر از طریق تماس با هاگهای این باکتری منتقل میشود و رایجترین راههای ابتلا به این بیماری از طریق تماس پوستی با هاگ باکتری است.
وی افزود: تماس مستقیم با پوست زخمی یا آسیبدیده هنگام دست زدن به گوشت، پوست یا پشم حیوانات آلوده از جمله گاو، گوسفند، بز و آهو باعث ابتلا به سیاهزخم پوستی، استنشاق هاگهای منتشر شده در هوا بویژه در هوای محیطهای صنعتی باعث سیاه زخم تنفسی میشود که بسیار خطرناکتر و کشندهتر است.
به گفته وی، خوردن گوشت آلوده یا مصرف محصولات حیوانی آلوده باعث سیاهزخم گوارشی میشود که علائمی مانند تهوع، استفراغ خونی، درد شکم و تب دارد.
رییس مرکز بهداشت چهارمحال و بختیاری گفت: دامداران، کارکنان دامپزشکی، کارگران صنایع چرم، پشم و پوست، کارکنان آزمایشگاههای تحقیقاتی و بیشترین خطر ابتلا را دارند.
وی با اشاره به اینکه پیشگیری از سیاهزخم (Anthrax) بر اساس کنترل منبع آلودگی و محافظت فردی انجام میشود گفت: واکسیناسیون دامها در مناطق بومی و آندمیک از مهمترین اقدامات در حوزه پیشگیری از ابتلا به سیاه زخم است.
صادقی افزود: کنترل و نظارت بر دامها از طریق قرنطینه دامهای مشکوک یا تازه وارد، معدومسازی مناسب لاشه حیوانات آلوده از طریق سوزاندن یا دفن عمیق همراه با آهک، خودداری از باز کردن لاشه حیوان مشکوک به سیاهزخم از دیگر راههای پیشگیری است.
به گفته وی، انجام محافظت فردی در محیطهای شغلی مانند استفاده از دستکش، ماسک، لباس محافظ و رعایت بهداشت فردی در تماس با پشم، پوست، یا فرآوردههای دامی، رعایت استانداردهای ایمنی زیستی در آزمایشگاهها و صنایع دامی، کنترل محصولات دامی و خودداری از مصرف گوشت خام یا مشکوک از حیوانات مرده یا بیمار و رعایت اصول بهداشتی در ذبح و توزیع گوشت دام از دیگر کارها و اقدامات پیشگیرانه است.
صادقی اطلاعرسانی و آموزش عمومی، آموزش دامداران و مردم روستاها درباره نحوه انتقال بیماری و نشانههای دام آلوده، آگاهیبخشی در مورد خطرات تماس مستقیم با لاشه حیوانات مرده، استفاده از آنتیبیوتیک از جمله سیپروفلوکساسین یا داکسیسایکلین به صورت پیشگیرانه برای افراد در معرض بیماری را ضروری دانست.
پربیننده ترین
-
عکس مسی درآمد؛ آخرین توپ طلا با آرایشگر ویژه!
-
10 جایزه 5 میلیون تومانی برای کاربران آخرین خبر (مهلت شرکت در مسابقه تا 9 آذر تمدید شد.)
-
10 جایزه 5 میلیون تومانی برای کاربران آخرین خبر (مهلت شرکت در مسابقه تا 9 آذر تمدید شد.)
-
چراغ قوه همه کاره ( پاور بانک، شیشه شکن و ... )
-
هشدار آبفای کشور به مردم؛ هیچ ماموری فعلا برای قرائت کنتور آب مراجعه نمیکند
-
آخرین وضعیت راهها در چهارمین روز از سال جدید؛ محور چالوس از شنبه دوباره بسته میشود
-
جارو شارژی !! دیگه نگران نظافت ماشین نباشید
-
زنده؛ بیرانوند در یک قدمی استقلال
-
"دنا پلاس اتومات" بخریم یا "تارا اتومات؟"/ مقایسه اختصاصی "آخرینخودرو" از دو خودروی پرطرفدار
-
فشار آبرو چند برابر کن ....
-
فرمانده کل قوا: ملت ایران در مقابل جنگ تحمیلی محکم میایستد همانگونه که در مقابل صلح تحمیلی نیز محکم خواهد ایستاد
-
چالش/ بازیکن داخل تصویر رو حدس بزن (16)
-
5 نشانه ضعیف شدن ریه ها و بهترین روش تقویت آن چیست؟
-
لندکروزر یا ۲۰۶؟ / مقایسه جالب "آخرینخودرو" به بهانه سخنان جنجالی میرسلیم
-
پایان زودهنگام گنبد آهنین؟ اسرائیل مجبور به جیرهبندی موشکها شد
-
سپ، برترین شرکت در خاورمیانه شد
-
واکنش عراقچی به تجاوز امروز آمریکا به تأسیسات هستهای فردو، نطنز و اصفهان
-
چالش/ بازیکن داخل تصویر رو حدس بزن (28)
آخرین اخبار
-
همدلی و آگاهی بانوان البرزی در پساجنگ تحمیلی اسرائیل و آمریکا
-
گرامیداشت شهدای اقتدار در بهاباد
-
تصویری روشن از «آینشتاین»
-
مراسم تشییع پیکر 3 شهید فراجا در چابهار برگزار شد
-
گولسیانی دوباره در باشگاه پرسپولیس!
-
تکنیکهای تماشایی و فراموش نشدنی زین الدین زیدان در یوونتوس
-
کار ساخت بازی Hell Is Us به پایان رسید
-
آسنسیو عذرخواهی کرد: در حد رئال نبودم
-
عامل تروریستی وابسته به سرویس بیگانه در مازندران دستگیر شد
-
یک دقیقه از جذابیت های بی ام و 760Li سری M
-
الهلال به سراغ مهاجم سابق یوونتوس رفت
-
حضور کریستیانو رونالدو در تریلر جدید بازی مبارزهای Fatal Fury
-
استارت تمرینات پیکان زیر نظر سعید دقیقی
-
پسانداز سلامتی در بانک خون بند ناف
-
رشد ۴ میلیون دلاری تراز تجاری خراسانشمالی در سایه صادرات هدفمند
سایر اخبار مرتبط
نظرات
ثبت نظر
مهمترین اخبار

جزئیات طرح جدید وزارت کار برای بیکاران مقرریبگیر
شنبه 22 تیر 1404 - 12:11:54

مدیرعامل بورس تهران: افت شاخص کل پس از بازگشایی کنترل شد
شنبه 22 تیر 1404 - 12:01:00

جزئیات بازسازی و نوسازی منازل آسیب دیده از جنگ در تهران
شنبه 22 تیر 1404 - 11:59:05

راهاندازی مجدد سامانه چکاپ رایگان با ظرفیت محدود ؛ ثبتنام سریعتر اولویت دارد
شنبه 22 تیر 1404 - 12:00:00

جزئیات بسته حمایتی بازار سهام در هفته جاری اعلام شد
شنبه 22 تیر 1404 - 11:36:54



